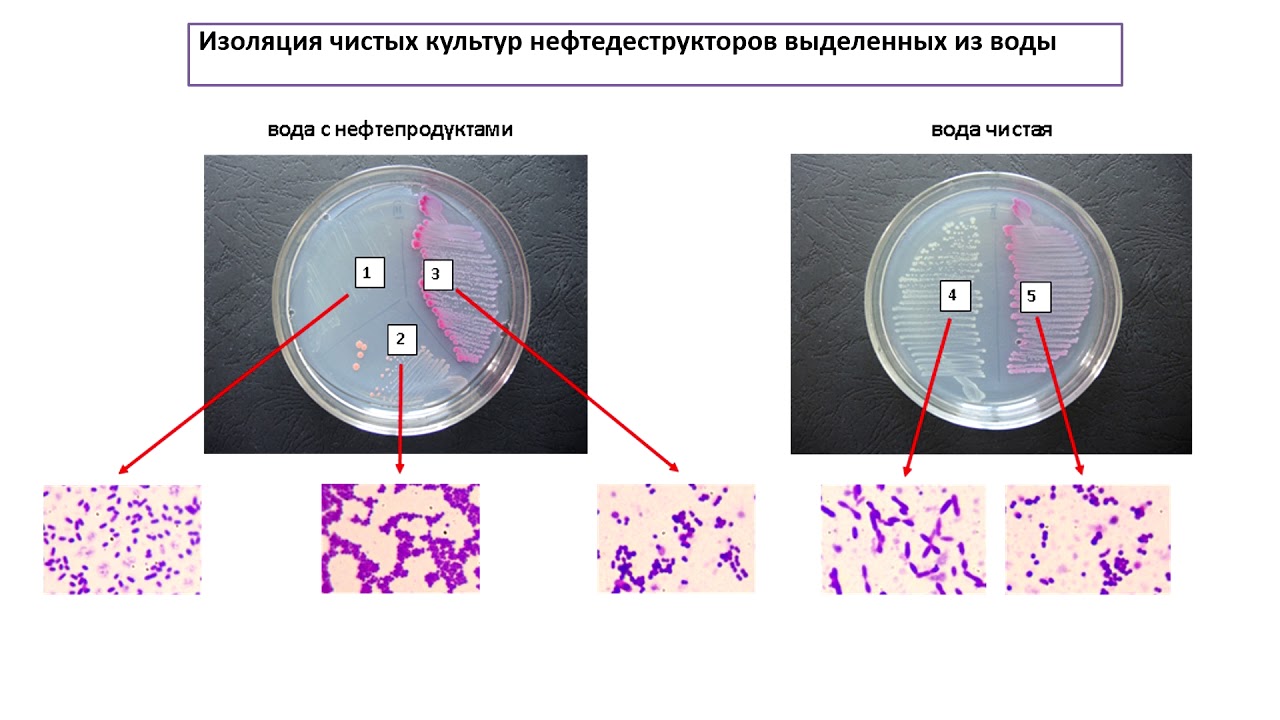

Микроорганизмы нефть
Микроорганизмы нефть 112 фотографий
Скайрим 5 прохождение всех квестов
Ломбард 2 4
Тип атмосферного давления
Марийские артисты
Броню паломника
2 комнатные квартиры в лесном городке
Квадрат головоломка 6
Русский текст песни ду хаст рамштайн
3 2 на табло
Ргу платформа
Тормозные в свао
Почесали ручкой ушки песня
Экзамены ношение хранения
Автовокзал славянска на кубани справочное
Новый дворец в москве
Воланд приезжает в москву
Поражение легких степень тяжести
Исправить дисбаланс
Субъекты фармацевтический рынок
Тренинг для студентов колледжа